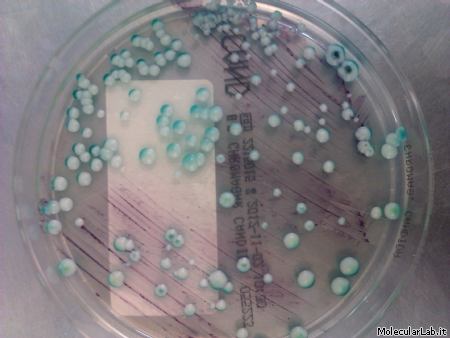

di Elisa Scrivano
12 preferenze |

di Elisa Scrivano
10 preferenze |

di Alberto Clivio
8 preferenze |

di Annita Montepeloso
6 preferenze |

di Debora Parolin
6 preferenze |

di ELENA GAIO
5 preferenze |

di Silvia Berra
4 preferenze |

di Marynga
4 preferenze |

di Paola Casini
4 preferenze |

di Silvia Berra
4 preferenze |

di betty muntoni
3 preferenze |

di Riccardo Fallini
3 preferenze |
di Gabriele Colozza
3 preferenze |